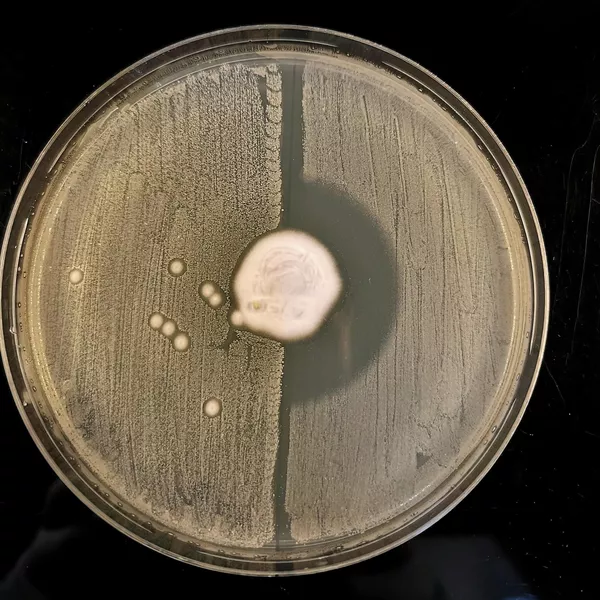

Антибиотики не помогут. На смену простым инфекциям идут супербактерии

За последние 50 лет у свиней, коров и других домашних животных из-за широкого применения антибиотиков сформировались новые штаммы микробов, чрезвычайно устойчивые к лекарственным препаратам. Некоторые уже приобрели способность переходить на людей. О том, как возникают супербактерии и в чем их опасность, — в материале РИА Новости.
Супербактериальная эпидемия
Бактериальные патогены, устойчивые к антибиотикам, называют резистентными или супербактериями. По данным ВОЗ, связанные с ними инфекции находятся на третьем месте среди причин смерти в мире после болезней сердца и инсульта. В 2019-м от них погибли 4,95 миллиона человек. Из-за постоянного роста резистентности микробов приходится назначать все более сильные препараты, увеличивать время пребывания в стационарах, повышать расходы на медицинскую помощь.
Супербактерии обычно связывают со злоупотреблением антибиотиками. Доказано, например, что устойчивость к этим препаратам приобрели бактерии Klebsiella pneumoniae, вызывающие пневмонию, сепсис, менингит, абсцессы печени, селезенки и другие опасные инфекции у новорожденных и пациентов отделений интенсивной терапии. Это произошло после того, как больным начали активно назначать препараты из семейства карбапенемов.
Фторхинолоны — антибиотики широкого спектра действия, которые применялись с 1980-х для лечения инфекций мочевыводящих путей, вызванных кишечной палочкой Escherichia coli, сегодня уже не помогают более чем половине пациентов. Стремительно падает эффективность цефалоспоринов, назначаемых при гонорее.
Но наибольшее беспокойство у специалистов вызывает метициллинрезистентный золотистый стафилококк (МРЗС). ВОЗ объявила эту супербактерию одной из самых серьезных угроз для здоровья человека.

Метициллинрезистентный золотистый стафилококк, увеличенный в 20 тысяч раз. Изображение сканирующего электронного микроскопа
МРЗС — устойчивая к большинству антибиотиков форма золотистого стафилококка (Staphylococcus aureus), вызывающая тяжелые заболевания. Чаще всего им заражаются в больницах и домах престарелых. В некоторых странах с этой бактерией связаны до 50 процентов внутрибольничных инфекций — пневмоний, послеоперационных раневых и кожных воспалений, инфекций мочеполовой системы и крови.
С 1990-х в Европе и США отмечают устойчивое увеличение случаев внебольничного заражения МРЗС — в детских учреждениях, тюрьмах, среди солдат и спортсменов — везде, где есть контакт через тело или одежду. Только в Америке от этого ежегодно умирают около 18 тысяч человек — на 64 процента больше, чем от нерезистентной формы стафилококка.
Эксперты ВОЗ считают, что стафилококковая эпидемия выходит из-под контроля. Устойчивые к противомикробным препаратам микроорганизмы обнаруживают в продуктах, растениях, воде, почве и воздухе. И как выяснилось, дело не только в антибактериальных препаратах.

Доля МРЗС среди всех внутрибольничных инфекций в странах Европы в 2017 году
МРЗС — устойчивая к большинству антибиотиков форма золотистого стафилококка (Staphylococcus aureus), вызывающая тяжелые заболевания. Чаще всего им заражаются в больницах и домах престарелых. В некоторых странах с этой бактерией связаны до 50 процентов внутрибольничных инфекций — пневмоний, послеоперационных раневых и кожных воспалений, инфекций мочеполовой системы и крови.
С 1990-х в Европе и США отмечают устойчивое увеличение случаев внебольничного заражения МРЗС — в детских учреждениях, тюрьмах, среди солдат и спортсменов — везде, где есть контакт через тело или одежду. Только в Америке от этого ежегодно умирают около 18 тысяч человек — на 64 процента больше, чем от нерезистентной формы стафилококка.
Эксперты ВОЗ считают, что стафилококковая эпидемия выходит из-под контроля. Устойчивые к противомикробным препаратам микроорганизмы обнаруживают в продуктах, растениях, воде, почве и воздухе. И как выяснилось, дело не только в антибактериальных препаратах.
Европейские и американские биологи под руководством Андерса Ларсена из датского Государственного института сыворотки установили, что МРЗС был в природе задолго до антибиотиков. Эту супербактерию нашли у лесных ежей.
Проследив генетическую историю патогена, ученые пришли к выводу, что резистентность Staphylococcus aureus — это адаптация к необходимости существовать бок о бок с грибком Trichophyton erinacei, живущим на коже животных. Этот грибок производит близкое пенициллину вещество, убивающее бактерии. В результате естественного отбора остались те, у которых был ген mecC.
Для проверки этой гипотезы провели эксперимент, поместив в лабораторные чашки вместе с Trichophyton erinacei как обычный золотистый стафилококк, так и его резистентный вариант. В первом случае через некоторое время все бактерии погибли, а во втором микроорганизмы продолжали расти.
В центре лабораторной чашки с агар-агаром расположен грибок Trichophyton erinacei. В правой половине, где были чувствительные к метициллину бактерии Staphylococcus aureus, все микробы погибли. В левой, где расположены МРЗС, продолжается бактериальный рост
Все антибиотики создают на основе природных соединений — например, пенициллин получают из плесневого гриба пеницилла. Вполне вероятно, что естественная устойчивость некоторых микроорганизмов к этим веществам возникла давно, а широкое применение антибактериальных препаратов способствовало переходу супербактерий на домашних животных и человека.

